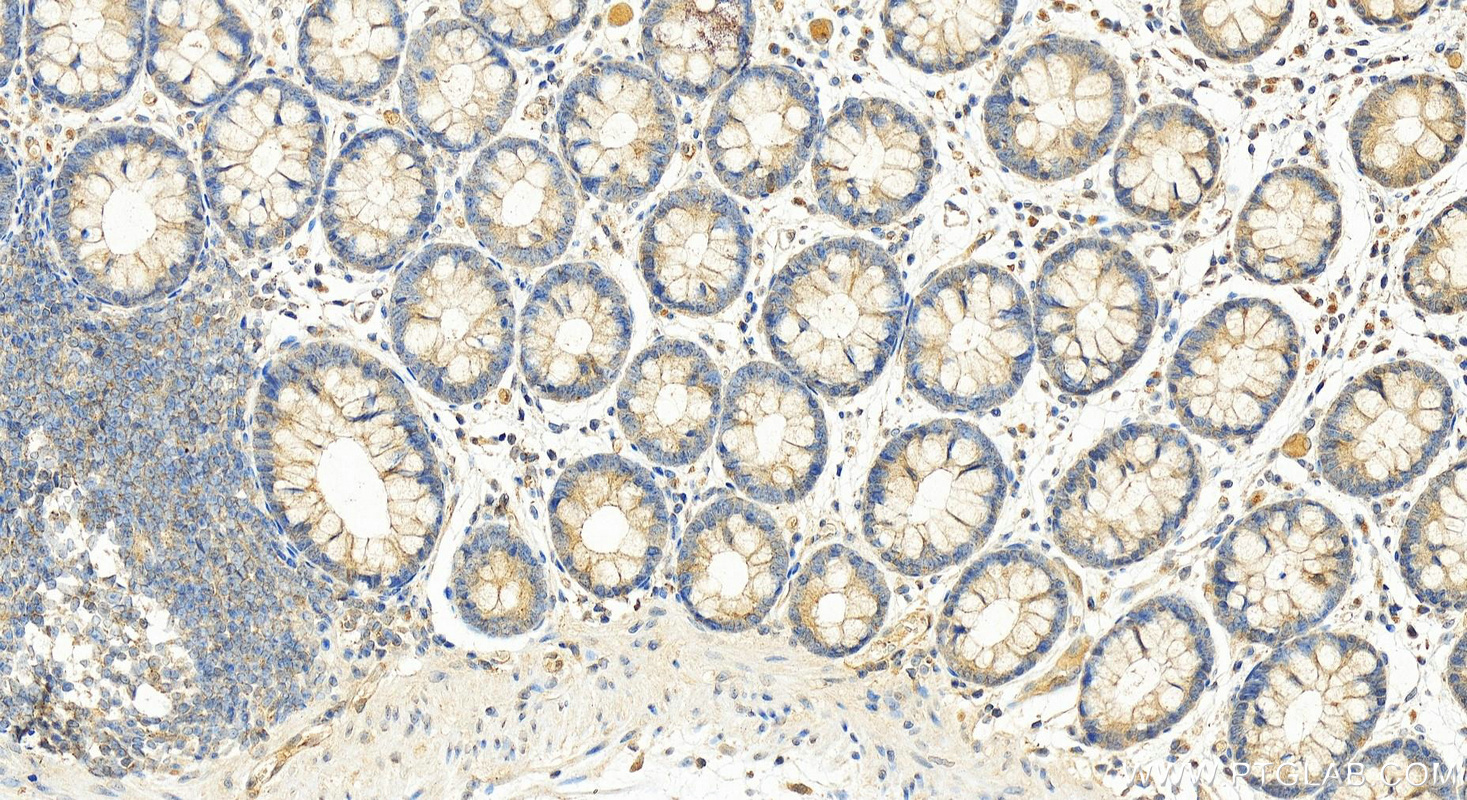

验证数据展示
经过测试的应用
| Positive WB detected in | A431 cells, HeLa cells, NIH/3T3 cells, THP-1 cells |
| Positive IP detected in | A431 cells |
| Positive IHC detected in | human colon tissue, human heart tissue Note: suggested antigen retrieval with TE buffer pH 9.0; (*) Alternatively, antigen retrieval may be performed with citrate buffer pH 6.0 |
推荐稀释比
| 应用 | 推荐稀释比 |
|---|---|
| Western Blot (WB) | WB : 1:1000-1:6000 |
| Immunoprecipitation (IP) | IP : 0.5-4.0 ug for 1.0-3.0 mg of total protein lysate |
| Immunohistochemistry (IHC) | IHC : 1:100-1:1200 |
| It is recommended that this reagent should be titrated in each testing system to obtain optimal results. | |
| Sample-dependent, Check data in validation data gallery. | |
产品信息
25068-1-AP targets RIG-1/DDX58 in WB, IHC, IP, ELISA applications and shows reactivity with human, mouse samples.
| 经测试应用 | WB, IHC, IP, ELISA Application Description |
| 文献引用应用 | WB, IHC, IP |
| 经测试反应性 | human, mouse |
| 文献引用反应性 | human, mouse, pig, monkey |
| 免疫原 |
CatNo: Ag18585 Product name: Recombinant human DDX58 protein Source: e coli.-derived, PGEX-4T Tag: GST Domain: 575-925 aa of BC132786 Sequence: RAAGFDEIEQDLTQRFEEKLQELESVSRDPSNENPKLEDLCFILQEEYHLNPETITILFVKTRALVDALKNWIEGNPKLSFLKPGILTGRGKTNQNTGMTLPAQKCILDAFKASGDHNILIATSVADEGIDIAQCNLVILYEYVGNVIKMIQTRGRGRARGSKCFLLTSNAGVIEKEQINMYKEKMMNDSILRLQTWDEAVFREKILHIQTHEKFIRDSQEKPKPVPDKENKKLLCRKCKALACYTADVRVIEECHYTVLGDAFKECFVSRPHPKPKQFSSFEKRAKIFCARQNCSHDWGIHVKYKTFEIPVIKIESFVVEDIATGVQTLYSKWKDFHFEKIPFDPAEMSK 种属同源性预测 |
| 宿主/亚型 | Rabbit / IgG |
| 抗体类别 | Polyclonal |
| 产品类型 | Antibody |
| 全称 | DEAD (Asp-Glu-Ala-Asp) box polypeptide 58 |
| 别名 | DDX58, RIG-I, Retinoic acid-inducible gene 1 protein, EC:3.6.4.13, DEAD box protein 58 |
| 计算分子量 | 925 aa, 106 kDa |
| 观测分子量 | 101~106 kDa |
| GenBank蛋白编号 | BC132786 |
| 基因名称 | RIG-1/DDX58 |
| Gene ID (NCBI) | 23586 |
| RRID | AB_2879881 |
| 偶联类型 | Unconjugated |
| 形式 | Liquid |
| 纯化方式 | Antigen affinity purification |
| UNIPROT ID | O95786 |
| 储存缓冲液 | PBS with 0.02% sodium azide and 50% glycerol, pH 7.3. |
| 储存条件 | Store at -20°C. Stable for one year after shipment. Aliquoting is unnecessary for -20oC storage. |
背景介绍
DDX58, also named as RIG-1, belongs to the helicase family. It is involved in innate immune defense against viruses. Upon interaction with intracellular dsRNA produced during viral replication, triggers a transduction cascade involving MAVS/IPS1, which results in the activation of NF-kappa-B, IRF3 and IRF7 and the induction of the expression of antiviral cytokines such as IFN-beta and RANTES (CCL5). Detects dsRNA produced from non-self dsDNA by RNA polymerase III, such as Epstein-Barr virus-encoded RNAs (EBERs). It is essential for the production of interferons in response to RNA viruses including paramyxoviruses, influenza viruses, Japanese encephalitis virus and HCV.
实验方案
| Product Specific Protocols | |
|---|---|
| IHC protocol for RIG-1/DDX58 antibody 25068-1-AP | Download protocol |
| IP protocol for RIG-1/DDX58 antibody 25068-1-AP | Download protocol |
| WB protocol for RIG-1/DDX58 antibody 25068-1-AP | Download protocol |
| Standard Protocols | |
|---|---|
| Click here to view our Standard Protocols |
发表文章
| Species | Application | Title |
|---|---|---|
Cancer Med RIG-I promotes IFN/JAK2 expression and the endoplasmic reticulum stress response to inhibit chemoradiation resistance in nasopharyngeal carcinoma. | ||
bioRxiv A tale of two tumors: differential, but detrimental, effects of glioblastoma extracellular vesicles (EVs) on normal human brain cells | ||
Proc Natl Acad Sci U S A IFIH1 (MDA5) is required for innate immune detection of intron-containing RNA expressed from the HIV-1 provirus | ||
Neurol Int Differential Effects of Extracellular Vesicles from Two Different Glioblastomas on Normal Human Brain Cells | ||
Virology Porcine epidemic diarrhea virus nsp14 inhibited IFN-Ⅰ production by targeting RIG-I for degradation | ||
bioRxiv Defect in hematopoiesis and embryonic lethality at midgestation of Vps13a/Vps13c double knockout mice |